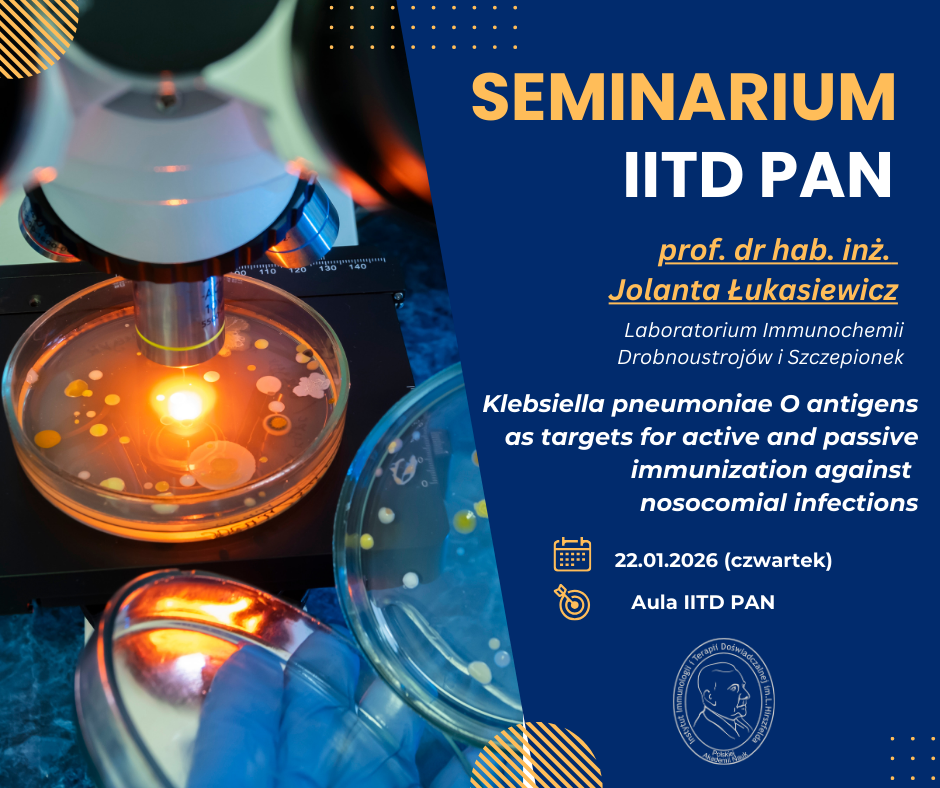

Zapraszamy na seminarium IITD, które odbędzie się 22.01.2026 r. (czwartek) o godz. 9:00 w auli Instytutu, w czasie którego prof. dr hab. Jolanta Łukasiewicz (Laboratorium Immunochemii Drobnoustrojów i Szczepionek) wygłosi wykład pt.: „Klebsiella pneumoniae O antigens as targets for active and passive immunization against nosocomial infections”.